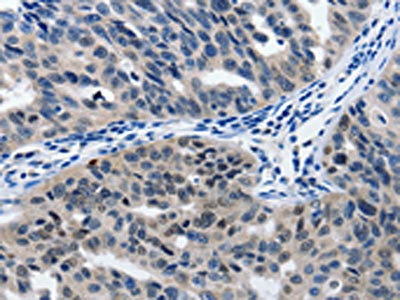

MATN1 Antibody
-
中文名稱:MATN1兔多克隆抗體
-
貨號:CSB-PA602770
-
規格:¥1100
-
圖片:
-
The image on the left is immunohistochemistry of paraffin-embedded Human brain tissue using CSB-PA602770(MATN1 Antibody) at dilution 1/60, on the right is treated with synthetic peptide. (Original magnification: ×200)
-
The image on the left is immunohistochemistry of paraffin-embedded Human ovarian cancer tissue using CSB-PA602770(MATN1 Antibody) at dilution 1/60, on the right is treated with synthetic peptide. (Original magnification: ×200)
-
-
其他:
產品詳情
-
Uniprot No.:
-
基因名:MATN1
-
別名:Cartilage matrix protein antibody; CMP antibody; CRTM antibody; Matn1 antibody; MATN1_HUMAN antibody; Matrilin 1 antibody; Matrilin 1 cartilage matrix protein antibody; Matrilin-1 antibody
-
宿主:Rabbit
-
反應種屬:Human
-
免疫原:Synthetic peptide of Human MATN1
-
免疫原種屬:Homo sapiens (Human)
-
標記方式:Non-conjugated
-
抗體亞型:IgG
-
純化方式:Antigen affinity purification
-
濃度:It differs from different batches. Please contact us to confirm it.
-
保存緩沖液:-20°C, pH7.4 PBS, 0.05% NaN3, 40% Glycerol
-
產品提供形式:Liquid
-
應用范圍:ELISA,IHC
-
推薦稀釋比:
Application Recommended Dilution ELISA 1:1000-1:5000 IHC 1:25-1:100 -
Protocols:
-
儲存條件:Upon receipt, store at -20°C or -80°C. Avoid repeated freeze.
-
貨期:Basically, we can dispatch the products out in 1-3 working days after receiving your orders. Delivery time maybe differs from different purchasing way or location, please kindly consult your local distributors for specific delivery time.
-
用途:For Research Use Only. Not for use in diagnostic or therapeutic procedures.
相關產品
靶點詳情
-
功能:Cartilage matrix protein is a major component of the extracellular matrix of non-articular cartilage. It binds to collagen.
-
基因功能參考文獻:
- polymorphisms associated with mandibular retrognathism PMID: 29407503
- Matrilin-1 is an inhibitor of neovascularization PMID: 24692560
- this meta-analysis found an overall significant association of rs1149048 polymorphism with risk of AIS, especially in Asian population. PMID: 24469715
- The A allele of single nucleotide polymorphism rs1065755 in the MATN1 gene is associated with adolescent idiopathic scoliosis. PMID: 22193623
- we concluded that MATN1 SNP is not associated with either adolescent idiopathic scoliosis predisposition or curve severity in Japanese. PMID: 21308753
- There is an association between matrilin-1 levels and curve progression in adolescent idiopathic scoliosis. PMID: 20137399
- Genotype GG of matrilin-1 gene is indicative of less bracing effectiveness in adolescent idiopathic scoliosis. PMID: 20137728
- Matrilin-1 A-domains have a role in cartilage ECM assembly PMID: 20729554
- Genotyping results showed Matrilin-1 polymorphism haplotype TGC (ht4; 158T, 7987G, and 8572C alleles) had pronounced risk effect for mandibular prognathism compared with controls. PMID: 20739701
- The tagSNP rs1149048 polymorphism in the MATN1 promoter region is associated with both susceptibility and disease severity in adolescent idiopathic scoliosis. PMID: 20092731
- Pseudoachondroplasia is associated with mutations in the cartilage oligomatrix protein gene. PMID: 15552564
- the tagSNP rs1149048 polymorphism in the MATN1 promoter region was associated with both susceptibility and disease progression in adolescent idiopathic scoliosis . PMID: 18985072
顯示更多
收起更多
-
亞細胞定位:Secreted, extracellular space, extracellular matrix.
-
數據庫鏈接:
Most popular with customers
-
-
YWHAB Recombinant Monoclonal Antibody
Applications: ELISA, WB, IHC, IF, FC
Species Reactivity: Human, Mouse, Rat
-
Phospho-YAP1 (S127) Recombinant Monoclonal Antibody
Applications: ELISA, WB, IHC
Species Reactivity: Human
-
-
-
-
-